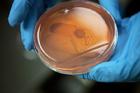
在接下來幾周，列印出來的靜脈放入另一個生長培養基。不久，細胞從水凝膠模子中倒出來，留下一個中空的血管細胞軟管。

發明
活體器官生物印表機基於現有技術發明,這些技術當前被用以製造工業零部件的3D模型。生物印表機的不同之處在於,它不是利用一層層的塑膠,而是利用一層層的生物構造塊,去製造真正的活體組織。這一技術尚處於初級階段,不過第一台活體器官生物印表機的原型機已在2009年底製造出來,並用以測試。
列印過程
活體器官生物印表機有兩個列印頭,一個放置最多達8萬個人體細胞,被稱為“生物墨”;另一個可列印“生物紙”。所謂生物紙其實是主要成分是水的凝膠,可用作細胞生長的支架。活體器官生物印表機使用來自患者自己身體的細胞,所以不會產生排異反應。據介紹,這種機器首先“列印”器官或動脈的3D模型,接著將一層細胞置於另一層細胞之上。列印完一圈“生物墨”細胞以後,接著列印一張“生物紙”凝膠。
不斷重複這一過程,直至列印完成新器官。隨後,自然生成的細胞開始重新組織、熔合,形成新的血管。每個血管大約需要一小時形成,而熔合在一起需要數天時間。
 將一個生物反應器放入孵化器中,與生長培養基反應,幾天后取出。生物反應器利用一種特殊的化學混合物,幫助細胞變成強有力的血管組織,這種混合物類似於細胞在人體生長時的情況。 將一個生物反應器放入孵化器中,與生長培養基反應,幾天后取出。生物反應器利用一種特殊的化學混合物,幫助細胞變成強有力的血管組織,這種混合物類似於細胞在人體生長時的情況。 |  將幹細胞從液氮池中取出。經過培養,幹細胞的數量會急速增加,然後再注入生物印表機。最終,這些細胞可以從患者身體各個部位——脂肪、骨髓和皮膚細胞——取出,製成起作用的靜脈。在幹細胞解凍以後,它們將在生長培養基中培養。這個步驟可以讓幹細胞不斷繁殖和生長,這樣,就可以用以形成靜脈。生長培養基還利用特製化學物令幹細胞長成所需要的類型,這種情況下則是血管細胞。一旦製作了足夠多的細胞,就可以用離心機將它們從生長培養基中分離出來,壓縮成顆粒狀。 將幹細胞從液氮池中取出。經過培養,幹細胞的數量會急速增加,然後再注入生物印表機。最終,這些細胞可以從患者身體各個部位——脂肪、骨髓和皮膚細胞——取出,製成起作用的靜脈。在幹細胞解凍以後,它們將在生長培養基中培養。這個步驟可以讓幹細胞不斷繁殖和生長,這樣,就可以用以形成靜脈。生長培養基還利用特製化學物令幹細胞長成所需要的類型,這種情況下則是血管細胞。一旦製作了足夠多的細胞,就可以用離心機將它們從生長培養基中分離出來,壓縮成顆粒狀。 |  生物列印過程的第一步是鋪設稱為水凝膠的材料,這種材料可當作支撐靜脈組織的臨時支架。定製生物印表機通過兩個泵壓頭,噴射出支架結構或細胞製成培養皿。泵壓頭安裝在一個高精度機器人裝配儀器上,令精度達到最大化。一個稱為生物反應器的小容器被用於模擬靜脈,它在列印靜脈之前就準備好了。生物反應器是生物科技體系中一個相當標準的部分,利用一塊鋁製造而成,這塊鋁圍繞在有許多連線埠的塑膠容器周圍。這些連線埠被用於抽出給生長的靜脈提供養料的化學物。在列印靜脈以前,技術人員用手將幾管培養好的細胞注入列印頭(與生物質列印墨盒相似)。 生物列印過程的第一步是鋪設稱為水凝膠的材料,這種材料可當作支撐靜脈組織的臨時支架。定製生物印表機通過兩個泵壓頭,噴射出支架結構或細胞製成培養皿。泵壓頭安裝在一個高精度機器人裝配儀器上,令精度達到最大化。一個稱為生物反應器的小容器被用於模擬靜脈,它在列印靜脈之前就準備好了。生物反應器是生物科技體系中一個相當標準的部分,利用一塊鋁製造而成,這塊鋁圍繞在有許多連線埠的塑膠容器周圍。這些連線埠被用於抽出給生長的靜脈提供養料的化學物。在列印靜脈以前,技術人員用手將幾管培養好的細胞注入列印頭(與生物質列印墨盒相似)。 |
 技術人員將一排排水凝膠平行放入培養皿盆的水槽里,在水槽中列印顆粒狀細胞圓柱體。至少一個水凝膠圓柱體被列印在細胞的中間位置,用於製作靜脈內的小孔,而血液最終將通過這個小孔流進流出。 技術人員將一排排水凝膠平行放入培養皿盆的水槽里,在水槽中列印顆粒狀細胞圓柱體。至少一個水凝膠圓柱體被列印在細胞的中間位置,用於製作靜脈內的小孔,而血液最終將通過這個小孔流進流出。 | 在接下來幾周,列印出來的靜脈放入另一個生長培養基。不久,細胞從水凝膠模子中倒出來,留下一個中空的血管細胞軟管。 在接下來幾周,列印出來的靜脈放入另一個生長培養基。不久,細胞從水凝膠模子中倒出來,留下一個中空的血管細胞軟管。 |  接著,再將列印出來的管狀細胞放入生物反應器。生物反應器將由蛋白、緩衝劑和其他多種化學物構成的特製混合物噴在列印好的靜脈中。這一步驟使得細胞可以變成功能可靠的靜脈,令其效用發揮到極致。 接著,再將列印出來的管狀細胞放入生物反應器。生物反應器將由蛋白、緩衝劑和其他多種化學物構成的特製混合物噴在列印好的靜脈中。這一步驟使得細胞可以變成功能可靠的靜脈,令其效用發揮到極致。 |
 在生物反應器內停留一段時間以後,顆粒狀細胞長在一起形成靜脈,然後就能植入患者體內。因為靜脈是從患者自己的細胞長出來的,他們的身體更有可能接受移植過來的靜脈,從而不會產生排異反應。 在生物反應器內停留一段時間以後,顆粒狀細胞長在一起形成靜脈,然後就能植入患者體內。因為靜脈是從患者自己的細胞長出來的,他們的身體更有可能接受移植過來的靜脈,從而不會產生排異反應。 |
套用
美國Organovo公司研製的活體器官生物印表機如今已經可以製造動脈,開發者稱由這種設備“列印”的動脈最早有望在5年內用於心臟搭橋手術。而心臟、牙齒和骨骼等更為複雜的器官則應該可以在10年內被“列印”出來。

